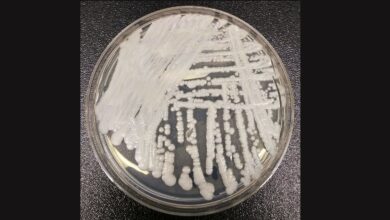

Υγεία
-

Candida Auris: Εφιάλτης στα νοσοκομεία με τον μύκητα που σκοτώνει το 60% των βαριά ασθενών – 100 κρούσματα τον μήνα στην Αττική
Φανταστείτε ένα δικό σας άτομο που παλεύει με τον καρκίνο και έχει αντέξει όλες τις φρικτές παρενέργειες από τα τοξικά…
Διαβάστε περισσότερα » -

Τακτικά Εξωτερικά Ιατρεία Νοσοκομείων: Πώς θα κλείνουν ραντεβού οι πολίτες με τους γιατρούς
Τη συμμετοχή όλων των γιατρών στη λειτουργία των Τακτικών Εξωτερικών Ιατρείων (ΤΕΙ) των Νοσοκομείων, καθορίζει η εγκύκλιος του υπουργείου Υγείας που υπογράφει ο…
Διαβάστε περισσότερα » -

Πάνω από 111.000 μαθητές χωρίς φαγητό με το πρώτο κουδούνι – SOS από 435 Νηπιαγωγεία για 15.500 παιδάκια
Με τις τιμές στα τρόφιμα, όπως τα γαλακτοκομικά, το κρέας, το ψάρι, τα φρούτα, να είναι απαγορευτικές για μεγάλο μέρος…
Διαβάστε περισσότερα » -

Ημικρανία: Ένα εκατομμύριο Έλληνες υποφέρουν από τη 2η αιτία αναπηρίας, με βαθύ κοινωνικό και οικονομικό αποτύπωμα
Έκκληση στην Πολιτεία απευθύνει ο Σύλλογος Ασθενών με Ημικρανία και Κεφαλαλγία Ελλάδος, για άμεσες μεταρρυθμίσεις στη διάγνωση και θεραπεία της νόσου από την…
Διαβάστε περισσότερα » -

Συναγερμός από το ECDC: «Υπερμύκητας» προσβάλλει τα νοσοκομεία στην Ευρώπη – Η Ελλάδα στις χώρες με τα περισσότερα κρούσματα
Ένας ανθεκτικός στα φάρμακα μύκητας εξαπλώνεται «ταχέως» στα νοσοκομεία σε όλη την Ευρώπη, με τις υγειονομικές αρχές να ζητούν πρόσθετες…
Διαβάστε περισσότερα » -

Κολλαγόνο: Ποιες τροφές ενισχύουν τη φυσική σύνθεσή του
Το κολλαγόνο έχει απασχολήσει επανειλημμένα την επιστημονική κοινότητα, λόγω των θετικών επιδράσεών του στο δέρμα, τις αρθρώσεις και τους τένοντες.…
Διαβάστε περισσότερα » -

Ιπποκράτειο: Ο γιος του ασθενή περιγράφει πώς «πιάστηκε στα πράσα» με το φακελάκι ο Δημήτρης Λυμπεριάδης
Την περιπέτεια υγείας του πατέρα του, που κατέληξε στη σύλληψη του διευθυντή της Καρδιοχειρουργικής Κλινικής του Ιπποκράτειου, περιγράφει ο γιος…
Διαβάστε περισσότερα » -

Αποκλειστικό – Ιπποκράτειο, η «σκοτεινή πλευρά»: Τα φακελάκια, οι καυγάδες και ένα πόρισμα – κόλαφος του 2016 που έμεινε στο συρτάρι
Μπορεί η είδηση της σύλληψης του γνωστού καρδιοχειρουργού στο Ιπποκράτειο Νοσοκομείο, που πιάστηκε επ΄ αυτοφώρω με «φακελάκι» να έσκασε σαν…
Διαβάστε περισσότερα » -

Διατροφική μάχη κατά της νόσου Alzheimer με λιγότερες θερμίδες
Μια πολλά υποσχόμενη μη φαρμακευτική στρατηγική για την επιβράδυνση της νόσου Alzheimer αποτελεί ο διατροφικός περιορισμός (Diet Restriction), όπως ο…
Διαβάστε περισσότερα » -

Πρωτοπαθής Χολική Χολαγγειίτιδα: Τι είναι και ποιοι κινδυνεύουν περισσότερο
Την ανάγκη ενημέρωσης και έγκαιρης διάγνωσης της Πρωτοπαθούς Χολικής Χολαγγειίτιδας (Primary Biliary Cholangitis – PBC), επισημαίνει η Ελληνική Εταιρεία Μελέτης…
Διαβάστε περισσότερα »